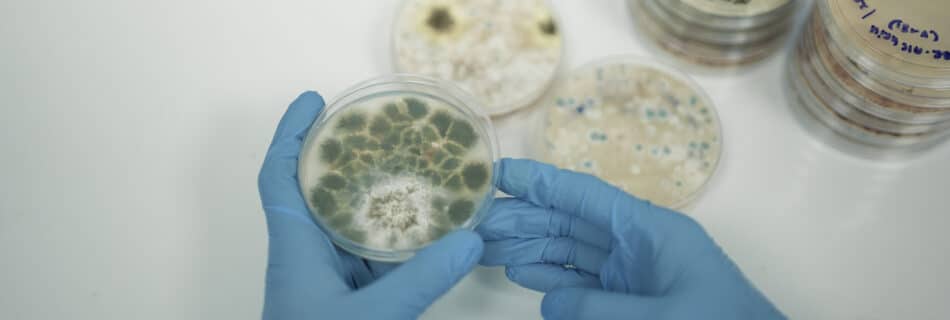

7 Smart Tips for Effective Mold Testing Dubai Every Family Needs
Table of Contents Comprehensive Approach to Mold Testing Dubai Understanding Mold Problems in Dubai Mold Testing Dubai Services Overview Step-by-Step Guide to Mold Testing in Dubai Advanced Techniques for Mold Detection in Dubai Mold Removal and Prevention Strategies in Dubai Conclusion and Next Steps Comprehensive Approach to Mold Testing in Dubai Mold assessment in Dubai …
Read more “7 Smart Tips for Effective Mold Testing Dubai Every Family Needs”